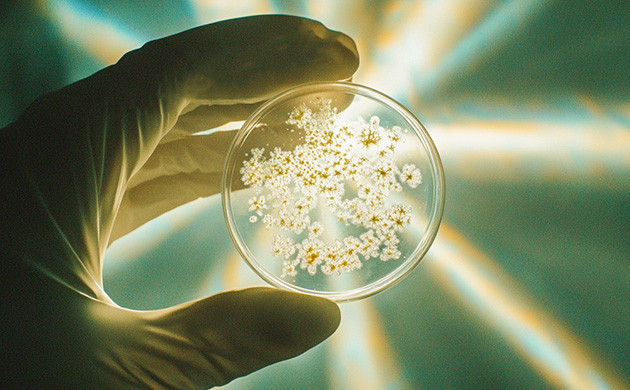
Насколько опасен фузариоз

Среди огромного разнообразия грибов далеко не все несут пользу для конопли. Конечно, некоторые из них очень полезны для здорового развития растишек. Например, микориза выступает отличной добавкой для улучшения качества почвы и положительно влияет на рост кустов каннабиса. Но есть целый ряд патогенных грибков, которые являются крайне губительными для растений. Один из таких – фузариум. Именно он вызывает заболевание фузариоз, способное быстро убить растихи. Если с ним не бороться, оно загубит весь урожай. В нашем материале мы подробно разберем все вопросы, связанные с грибковым фузариозом.
Что такое фузариум?

Fusarium – это род почвенных грибов. Существует множество различных видов фузариума, которые распространены по всему миру. В чем заключается его опасность? Когда фузариум поражает растения, он становится патогеном и может значительно навредить ратсихам на любом этапе развития.
Одна из особенностей фузариума заключается в том, что он может годами сохраняться в почве в спящем состоянии. На самом деле это довольно распространенное явление. Однако при возникновении благоприятных условий он начинает развиваться и уничтожать все на своем пути. И для вашего растения это может стать настоящим испытанием, которое переживет далеко не каждый кустик.
Насколько опасна фузариозная плесень?
Фузариозная плесень – это вид плесени, поражающий множество различных растений, в том числе и коноплю. На зараженных культурах может развиваться нездоровое основание главного стебля, а также сильно пораженные корни. Существует множество штаммов этой плесени, и она может быть разного цвета, включая белый, зеленый, красный, светло-коричневый или бледно-желтый. Фузариозная плесень обычно «обитает» в почве и растениях, но может развиваться и в помещениях.
Большой проблемой является тот факт, что она очень опасна не только для растишек, но и для человека. Фузариозная плесень даже использовалась в качестве биологического оружия в военных действиях. Она может поражать организм, если споры попадают в дыхательные пути или вместе с продуктами питания. Именно поэтому гроверам крайне важно осознавать все риски, связанные с использованием шишек, которые поражены любым видом плесени и выглядят нездоровыми.
Поражение растений конопли фузариумом приводит к заболеванию, известному как фузариозное увядание. Сам патоген прикрепляется к корневой системе, лишая растение жизненно важных питательных веществ, необходимых ему для здорового развития. В результате конопля становится слабой и без необходимых ресурсов быстро увядает. В свою очередь, это не просто мешает растихе нормально развиваться, а зачастую приводит к его полной гибели, а гровера лишает долгожданного урожая.
Причины развития фузариозной плесени и признаки фузариозного увядания конопли
Существует две основные причины: изначально зараженные семена или зараженная почва, из которой фузариум поражает корни растений конопли. Как уже описывалось выше, поражая корневую систему, патоген не даёт ей усваивать питательные вещества, что быстро приводит к нарушениям в развитии всех частей растения. Фузариум ограничивает их способность проводить воду и питательные вещества. Это смертоносное сочетание повреждает каннабис изнутри и фактически убивает его. В результате растиха становится слабой и увядающей, расходуя все свои силы на борьбу за выживание.
Фузариозное увядание быстро проявляется на растении. В первую очередь отмирают листья: они быстро увядают и желтеют. Некоторые штаммы фузариума также приводят к корневой гнили. В таком случае корневая система приобретает красный цвет, а затем красноватый оттенок появляется на стебле и других надземных частях растения. Если вы заметите следующие признаки на своих кустах, то у нас для вас плохие новости:

Общее увядание;
Красный оттенок стебля и ветвей;
Красный оттенок корней;
Вздутый стебель;
Надломы на стебле;
Желтый и желто-коричневый цвет листвы;
Коричневые точки на нижних листьях;
Скручивание листвы кверху.
Помните! Каннабис, зараженный фузариозом, может нанести значительный вред организму! Вдыхание спор фузариума крайне опасно. Поэтому внимательно следите за своими растихами, чтобы обнаружить первые признаки плесени и принять соответствующие меры.
Как предотвратить развитие фузариоза?
Аэробные условия культивации

В борьбе с таким недугом, как фузариоз, важно понимать, что существуют и грибки, которые благотворно влияют на каннабис. В этой связи нужно предпринимать такие меры, чтобы предотвратить или как минимум усложнить развитие именно вредных разновидностей грибка в целом и фузариума в частности.
Простой и полезный способ снизить риск развития фузариоза – обогащать почву достаточным количеством кислорода. Большинство разновидностей фузариума более комфортно чувствуют себя в анаэробной почве, то есть в почве с недостаточным количеством кислорода. Безусловно, этот вид грибка способен развиваться и в аэробной среде, но всё же высокое содержание кислорода и насыщенность им почвы снижает риск развития патогенных анаэробных штаммов.
Вентиляторы на полную!

Больше всего на развитие фузариума благоприятно влияют два условия: тепло и влага. И это особенно проблематично в гроубоксах и гроурумах, где лампы могут нагревать почву, а влажность иногда выбивается из-под контроля. Внимательно следите за этими двумя показателями. Ну а лучшим способом контроля будет хорошая вентиляция и обдув площади культивации. Установите вентилятор или вентиляторы внутри гроубокса так, чтобы растихи всегда хорошо обдувались и в них не задерживалась лишняя влага после полива. Кроме того, это понизит температуру на градус-другой.
Купите гигрометр – он стоит совсем недорого, но с ним вы всегда будете знать текущий уровень влажности. На начальных этапах грова рекомендуется придерживаться показателей в 70% и постепенно снижать до 40%. Хорошо зарекомендовала себя практика понижения уровня влажности на 5% каждую неделю, но не ниже 40%.
Хороший дренаж почвы

Многие гроверы, особенно новички, сильно недооценивают важность дренажа почвы. Из-за этого часто возникают проблемы с поливом: в горшках скапливается лишняя влага. Такие условия являются оптимальной средой для развития патогенных грибков. Помните: чем больше в почве воды, тем меньше в ней кислорода. Однако избежать таких проблем максимально просто. Во-первых, не забывайте добавлять в почвосмесь ингредиенты для улучшения дренажных свойств. Найти подробные инструкции по этому поводу вы можете на нашем форуме. Что касается полива, то давать очередную порцию воды стоит только в том случае, если почва полностью просохла.
Использование здоровой почвы с полезными микроорганизмами

Баланс – ключ к успеху. Важно, чтобы в почве не доминировал какой-то один вид микроорганизмов. Необходима сбалансированная пропорция полезных бактерий и полезных грибков. Любой перекос в ту или иную сторону – это не очень хорошо. Для того чтобы добиться необходимого баланса и правильного состава почвы, можно использовать следующие способы:
Полив растения компостным чаем;
Добавление богатой на полезные бактерии жидкой патоки.
Если вы с самого начала создадите здоровые условия в почве, то вероятность развития патогенных грибков будет гораздо ниже. Это похоже на собственную природную систему сдержек и противовесов. Разнообразные микроорганизмы в почве помогут создать оптимальную пищевую сеть. Это значит, что микробы будут работать на пользу растения, а не наоборот. Важно не переусердствовать, иначе можно добиться противоположного результата.
В исследовании, опубликованном в журнале Applied Soil Ecology в 2014 году, сравнивалась органическая почва со здоровой микробиологией и обычная почвы без неё. В частности, изучалось, насколько хорошо эти два типа почв противостоят заражению льна фузариозом. Угадайте, что? Органическая почва победила. Она имела более здоровую почвенную микробиоту, что позволило ей лучше подавлять фузариоз, чем неорганическая почва.
Меняйте место высадки в аутдоре

При культивации конопли на улице избегайте высадки растишек в одном и том же месте. Как и в традиционном сельском хозяйстве, одну и ту же культуру лучше не выращивать на одном поле, даже два сезона подряд. Всё дело в том, что если в почве остались микроорганизмы и грибки, которые уже приспособились к конкретному растению, в нашем случае к каннабису, то они с большей вероятностью поразят их в следующий раз.
Еще один вариант – высаживать каннабис вперемешку с другими культурами. Конечно, можно подобрать исключительно растения-компаньоны, которые благотворно влияют на состояние почвы, отпугивают вредителей и т.д. Это достаточно обширная тема и она заслуживает отдельного материала. Но в целом реализовать такой вариант очень просто. Если у вас есть возможность высадить кустик конопли среди других культур, это будет хорошей идеей. Растихи естественным образом создают свою уникальную экосистему, сообща борясь не только с вредителями, но даже с патогенными микроорганизмами.
Важность уровня pH

Такой неприметный показатель, как уровень pH, часто ускользает от внимания гроверов, особенно в начале коноплеводческой карьеры. На самом деле это очень важный аспект культивации конопли как с точки зрения усвоения питательных веществ, так и с точки зрения общего здоровья растишек. В контексте описываемой темы уровень кислотности играет витальную роль. Фузариум лучше всего развивается при показателях pH до 6, что совпадает с оптимальными показателями для конопли. Однако наше любимое растение отлично чувствует себя и при числах в 6.3-6.5, а вот патогенный грибок – не очень. Конечно, это не панацея и не гарантированный план по предотвращению развития фузариума, но может помочь. Чем выше уровень pH – тем сложнее грибку развиваться.
Способы борьбы с фузариозом
К большому разочарованию гроверов, действенных способов вылечить пораженное фузариозом растения нет. Причем с данной напастью борются не только коноплеводы, но вся сельскохозяйственная отрасль в целом. Не помогают ни пестициды, ни другие способы. Только превентивные меры и профилактика. Поэтому мы собрали несколько основных рекомендаций, которые важно знать, чтобы избежать заражение растений фузариозом и уберечь свой урожай от этой напасти:

Ни в коем случае не используйте почву, в которой росло зараженное растение. Если фузариум поселился в грунте, он никуда из него не денется и будет обитать в нём долгие годы. Единственный действенный метод – избавиться от зараженной почвы и в целом не практиковать использование одного грунта несколько раз. Это будет отличной профилактикой;
Не выращивайте несколько растений в одном большом контейнере. Изолированная среда развития для каждого куста не позволит фузариуму быстро перекинуться с одного растения на другое;
При обнаружении зараженных растений сразу избавляйтесь от них. К большому сожалению, вылечить фузариоз не представляется возможным. Учитывая то, что он поражает корневую систему, единственным действенным способом будет не просто изоляция растения или обрезка больных частей, а полное его уничтожение. Лучше всего сжечь больную растиху подальше от своего сада, после чего тщательно продезинфицировать все инструменты, которые использовались в работе с ним;
Тщательно убирайте и мойте свой гроубокс после каждого цикла. Порядок и чистота площади культивации крайне важна для здорового развития кустиков. Не поленитесь принять за правило тщательную уборку и дезинфекцию «рабочего места» после каждого цикла и перед началом нового. Таким образом вы избавитесь от возможных остатков патогенных микроорганизмов, которые остались на стенках гроубокса или оборудовании;
Еще раз внимательно перечитайте эту статью и примите к сведению все данные в ней рекомендации.
Сорта конопли с крепким иммунитетом
Несмотря на свою природную жизнестойкость, каннабис подвержен разным заболеваниям. Селекционеры из разных сидбанков трудятся не покладая рук над созданием универсального сорта, который бы совсем не болел, не стрессовал и рос, где угодно. Звучит как что-то нереальное, не так ли? Но если задуматься, то очень надёжное, стойкое и крайне неприхотливое растение давно известно широким кругам. Это легендарный сорт Northern Lights и гибриды на его основе. Предлагаем вашему вниманию небольшую подборку лучших экземпляров конопляного «Северного Сияния».

- Фотопериодные
- 20 %
- Сильный эффект
- Индор: 500 г/м² Аутдор: 800 г/куст
Сорт конопли Skunk 47 от испанского сидбанка World Of Seeds – результат слияния двух классических генетик: Skunk #1 с его мощным high-эффектом и AK-47, давно зарекомендовавшей себя надежностью и стабильностью. Иммунитет у этого каннабиса по-настоящему крепкий – устойчивость к плесени, насекомым-вредителям и внешним стрессам унаследованы от AK-47. Новичок может работать с ним без лишней тревоги, а опытный гровер оценит предсказуемость и итоговый результат. Кусты вырастают невысокими и пышными с типичной индичной структурой, развиваются одинаково уверенно в индоре и аутдоре. Цветение занимает 55-60 дней, что открывает возможности для культивации в умеренном климатическом поясе. Урожайность в помещении достигает 500 грамм шишек на 1 м², а на улице с куста снимают до 800 грамм. Терпеновый профиль строится на остроте, кофейных нотках и фруктовых оттенках – многослойно, с характером, без лишней сладости. ТГК в 20% реализуется в сбалансированный эффект с волнообразной динамикой. Сначала приходит воодушевляющий эйфорический high: настроение поднимается, мысли ускоряются. Затем в дело вступает расслабляющий stone: тело избавляется от напряжения, стресс и болевые ощущения уходят безвозвратно. Отдых, веселое времяпровождение и даже помощь при бессоннице – этот гибрид справляется с каждым из этих вариантов.

- Автоцветущие
- 17 - 19 %
- Мягкое расслабление
- Индор: 600 - 800 г/м² Аутдор: 75 - 200 г/куст
Сорт конопли Fast & Vast Auto от Heavyweight Seeds построен на тройном скрещивании генетик Afghani, White Dwarf и Skunk. Сначала из первых двух был создан промежуточный гибрид, а затем его усилили афганской индикой. Именно она добавила автоцвету живучесть, мощный иммунитет и устойчивость, делающую это растение практически неубиваемым в любых условиях. Иммунитет здесь действительно крепкий – одна из ключевых причин, по которой Fast & Vast Auto рекомендуют и коммерческим производителям, и тем, кто впервые держит семена в руках. Кусты вырастают пышными и разветвленными, до 100-120 сантиметров в высоту. Весь цикл от семени до харвеста занимает около 56 дней – быстро и предсказуемо. После сбора урожая можно будет насладиться чудесным ароматом, который еще на этапе цветения удивляет яркими нотками пряностей. Воздействие же реализуется через мягкий и обволакивающий стоун. С ним тело расслабляется постепенно, а стресс и нервное напряжение уходят моментально. Сознание отправляется в спокойное длительное путешествие, а на душе устанавливается равновесие – именно то состояние, ради которого этот автоцвет и выбирают снова.

- Автоцветущие
- 26 %
- Эйфория и глубокий телесный релакс
- Индор: 400 - 650 г/м² Аутдор: 200 - 400 г/куст
Сорт конопли Acid Rain Autoflower от Easy Grow Seeds – прямой потомок двух легендарных генетик: LSD и Super Magnum Auto. Оба родителя обладают солидной репутацией, а их объединение дало автоцвет с психоделическим потенциалом и при этом предельно простым характером. На стадии рассады стоит уделить условиям чуть больше внимания, а дальше растение само берет ситуацию под контроль: непогода, холода, ветер и мелкие погрешности в уходе переносятся без серьезных последствий. Кусты вырастают до отметки в 150 сантиметров с пышной, аккуратной структурой и плотными бутонами. Полный жизненный цикл длится от 8 до 9 недель. Урожайность в закрытом грунте составляет 400-650 г/м², тогда как на открытом воздухе можно собрать 200-400 г/куст. В гидропонике потенциал гибрида раскрывается полностью. Терпеновый профиль строится на альфа-гумулене, линалооле и мирцене: сладко-землистая основа с резкими сканковыми нотками. Уровень ТГК достигает 26%, а воздействие приходит поэтапно. Сначала стоит ожидать будоражащее церебральное путешествие с психоделическими оттенками и эйфорией. Сознание выходит за привычные рамки, восприятие обостряется. А когда высокий подъем идет на спад, его сменяет глубокое физическое расслабление. Дневной формат здесь уместнее, но с количеством стоит быть внимательным – эффект мощный.

- Автоцветущие
- 24 %
- Мощное расслабление
- Индор: 650 г/м² Аутдор: 50 - 170 г/куст
Сорт конопли Tashkenti Auto от Семяныча – автоцветущая индика с корнями в горных районах Узбекистана, усиленная отборным рудералисом. Такое происхождение наложило отпечаток на все его характеристики, обеспечив стабильностью, устойчивостью и способностью справляться с условиями, в которых большинство растений начинает страдать. Иммунитет у него действительно крепкий, поэтому с культивацией без проблем справляются даже малоопытные новички. Горная индика веками адаптировалась к засухе, перепадам температур и бедным почвам, и Tashkenti Auto сохранил эти качества в полной мере. Нестабильная погода, холода, ошибки в питании – все это растение переносит без драмы и продолжает свой путь к харвесту. Кусты вырастают до 80-160 сантиметров как в помещении, так и на улице. Вкусоароматический профиль сорта неожиданный для горной индики: сладкие тропические ноты с банановым оттенком. Эффект реализуется через глубокое седативное воздействие. Мышцы расслабляются быстро и полностью, веки тяжелеют, ход времени замедляется, качество сна улучшается, болевые ощущения и напряженность уходят. Вечерний формат здесь единственно верный.

- Фотопериодные
- 22 %
- Мощное расслабление
- Индор: 500 г/м² Аутдор: от 500 г/куст
Сорт конопли Cookies Purple Punch представляет собой разработку испанского сидбанка Medical Seeds, созданную на основе двух генетик: GMO Garlic Cookies и Purple Punch 2.0. Индика-доминантный гибрид взял от первого родителя пряный характер и глубокий эффект, а от второго – фиолетовую эстетику и устойчивость к угрозам. Крепкий иммунитет является одним из главных его преимуществ. Кусты стойко переносят перепады температуры и плохую погоду, а ошибки в уходе прощают без серьезных последствий. Такое сочетание жизнестойкости и предсказуемости делает его одинаково привлекательным для новичка и для опытного садовода. Структура у растишек приземистая и крепкая, тренировки они принимают без сопротивления – как низкострессовые, так и более интенсивные. Аромат у шишек Cookies Purple Punch специфический и нестандартный. В нем улавливаются нотки свежего лука и чеснока от линейки GMO. Во вкусе это смягчается – пряные тона выходят на первый план, создавая необычный, но запоминающийся профиль. Воздействие обеспечивает продолжительный расслабляющий эффект. Тело постепенно тяжелеет, напряжение уходит, сознание замедляется до спокойного и комфортного ритма.
*Вся представленная информация носит исключительно ознакомительный характер и не является руководством или призывом к действию.
**Напоминаем, что использование семян марихуаны в качестве посевного материала (выращивание конопли с целью получения растения) запрещено УК Российской Федерации. Подробнее с законом Вы можете ознакомиться здесь.











Все комментарии проходят модерацию. Правила для публикаций:
Общие вопросы, не относящиеся к статье, также будут удалены.